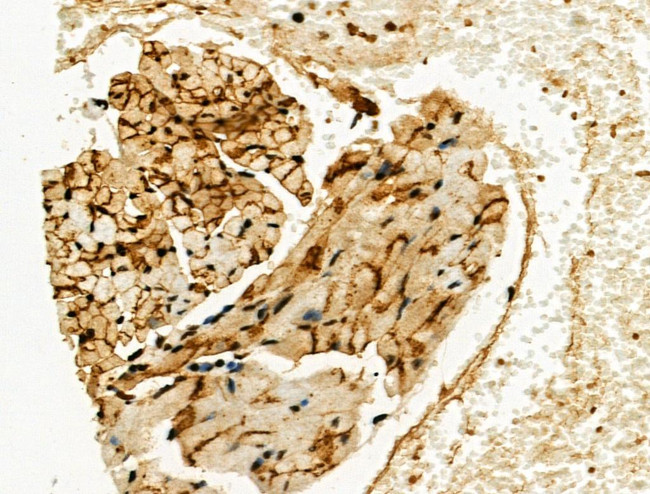
Phospho-Connexin 43 (Ser373) Antibody in Immunohistochemistry (Paraffin) (IHC (P))

Search
Invitrogen
Phospho-Connexin 43 (Ser373) Polyclonal Antibody
{{$productOrderCtrl.translations['antibody.pdp.commerceCard.promotion.promotions']}}
{{$productOrderCtrl.translations['antibody.pdp.commerceCard.promotion.viewpromo']}}
{{$productOrderCtrl.translations['antibody.pdp.commerceCard.promotion.promocode']}}: {{promo.promoCode}} {{promo.promoTitle}} {{promo.promoDescription}}. {{$productOrderCtrl.translations['antibody.pdp.commerceCard.promotion.learnmore']}}
图: 1 / 3
Phospho-Connexin 43 (Ser373) Antibody (PA5-105989) in IHC (P)



Please note: We are reviewing Western blot images included in the antibody testing data in our catalog, including those provided by third parties. Unless expressly labeled or annotated as “raw-unedited”, Western blot images included in the antibody testing data in our catalog may have been edited, optimized or otherwise adjusted for presentation.
产品信息
PA5-105989
种属反应
宿主/亚型
分类
类型
抗原
偶联物
形式
浓度
规格
纯化类型
保存液
内含物
保存条件
运输条件
RRID
产品详细信息
Antibody detects endogenous levels of Connexin 43 / GJA1 only when phosphorylated at Ser373.
靶标信息
Connexin 43 (Cx43) is a member of the gap junction protein family. Connexins assemble as a hexamer and are transported to the plasma membrane to create a hemichannel that can associate with hemichannels on nearby cells to create cell-to-cell channels. Clusters of these channels assemble to make gap junctions. Gap junction communication is important in development and regulation of cell growth. Phosphorylation of Cx43 is important in regulating assembly and function of gap junctions. Ser368 of Cx43 is phosphorylated by protein kinase C (PKC) after activation by phorbol esters, which decreases cell-to-cell communication. Src can interact with and phosphorylate Cx43 to alter gap junction communication. GFAP are membrane-spanning proteins that facilitate the transfer of ions and small molecules between cells. According to sequence similarities at the nucleotide and amino acid levels, the gap junction proteins are divided into two categories, alpha and beta. Connexin 43 is the major protein of gap junctions in the heart, and gap junctions are thought to have a crucial role in the synchronized contraction of the heart and in embryonic development. Connexin 43 is also targeted by several protein kinases that regulate myocardial cell-cell coupling. A related intron-less connexin 43 pseudogene, GJA1P, has been mapped to chromosome 5. Mutations in the GFAP gene cause X-linked Charcot-Marie-Tooth disease, an inherited peripheral neuropathy, oculodentodigital dysplasia and heart malformations. Alternatively spliced transcript variants of GFAP have been found.
仅用于科研。不用于诊断过程。未经明确授权不得转售。
篇参考文献 (0)
生物信息学
蛋白别名: alpha 1 connexin; connexin 43; Connexin-43; Cx-43; Cx43; CXA1; DFNB38; Gap junction 43 kDa heart protein; Gap junction alpha-1 protein; gap junction membrane channel protein alpha 1; ODD; ODOD; SDTY3; Syndactyly type III
基因别名: AU042049; AW546267; Cnx43; connexin43; Cx43; Cx43alpha1; Cxn-43; Gja-1; GJA1; GJAL; Npm1
UniProt ID: (Mouse) P23242, (Rat) P08050
Entrez Gene ID: (Mouse) 14609, (Rat) 24392